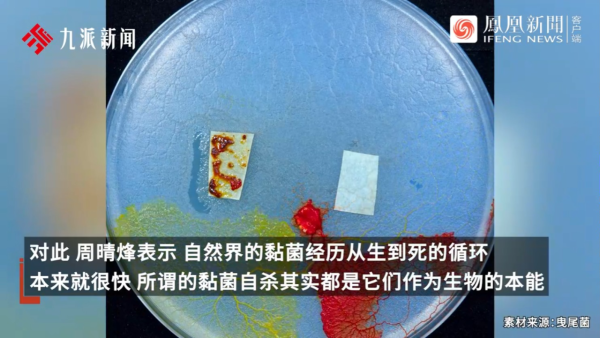
內地景區推古代坐監沉浸式體驗 還原《甄嬛傳》劇情 網民：凍死了有人知道？
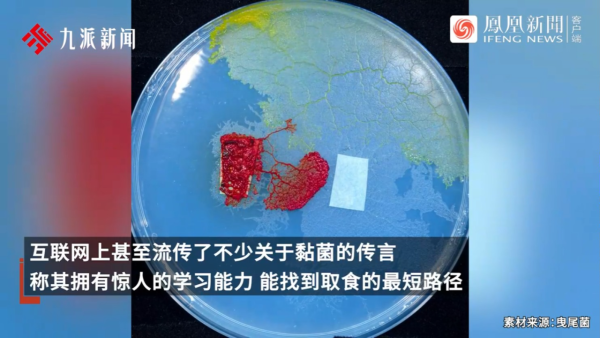
內地景區推古代坐監沉浸式體驗 還原《甄嬛傳》劇情 網民：凍死了有人知道？
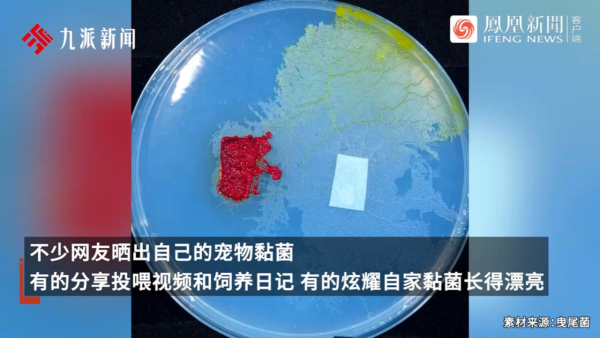
內地景區推古代坐監沉浸式體驗 還原《甄嬛傳》劇情 網民：凍死了有人知道？

為了刺激旅遊和客流,許多旅遊公司或旅遊局都絞盡腦汁,推出新式旅遊主題。最近內地黑龍江省的牡丹江鏡泊湖旅遊集團就隆重推出「流放寧古塔」,成為繼遼寧本溪「當野人」、山東臨沂「攻打縣城」等沉浸式項目後的又一新奇體驗。
▶立即下載U Lifestyle App:https://bit.ly/47MZ5J2
同場加映:【快閃旅行團】最新影片
近年,市面上多了深度遊、生態遊、交友遊等,但舉辦在冰天雪地上的監獄流放遊,能體驗古代囚犯的煎熬,大家又有沒有興趣試?
▼景區推監獄沉浸式體驗▼
對於監獄流放體驗,普遍網民持正面態度,表示想玩,又提議:「不要賣美食,給點冷窩頭吃就行」;但也有人擔心:「若是凍死在這裡,可有人知道」。
▼點擊查看網民留言▼
來源:微博、牡丹江鏡泊湖旅遊集團、小紅書
最近本地多個社交平台瘋傳幾張照片,原來有內地女子在商場、陸路邊境口岸附近高舉心型紙牌公開徵婚,而且徵婚要求條件並不高,她強調錢財都不是重點,「只要是香港的就行」?
▼按圖看完整事件▼
內地女出沒各大內地商場、蓮塘口岸
記者翻查資料,發現早在10日抖音上已出現相關影片,影片長約6秒左右,拍攝地點為蓮塘口岸附近。當時女子身穿同款黑色緊身T恤和牛仔褲,在人來人往的通道高舉愛心紙牌,雖然人潮眾多,但未有人理會她。
港人提醒便宜莫貪:結婚期限係七年
照片在網上掀起關注,有網友隨即表示「佢倒貼幾多先?」、「免費是最貴」,提醒港人要小心被騙。亦有網友表示是簡直是一眾宅男的救星,但溫馨提醒這段婚姻是有期限,「移民一條龍」、「結婚期限係七年」,並詳細解釋「與內地人結婚5大流程」。
▼按圖看網友留言▼
▼網友詳細解釋「與內地人結婚5大流程」▼
網友想起何伯何太事件:大量生產河馬河太
此外,亦有網友想起今年引發全城熱話的何伯何太事件,紛紛表示「大量生產河馬河太」、「何伯揼春」,亦有人指出該名內地女「仲直接過河太」,甚至把她形容是「小河馬」。
來源:FB@大埔人大埔谷、FB@全港店舖消息(+時事熱話) 關注組 2.0 關注組、FB@西環變幻時、抖音
隨著養寵物的潮流不斷演變,近年來中國年輕人開始養一種新型的「寵物」——黏菌。這種生物不僅無毒無害,還因其獨特的生長方式和低維護成本而受到廣泛關注。許多網友在社交平台上分享他們的飼養經驗,引發了熱議。
黏菌的基本特徵
黏菌並不屬於真菌或細菌,而是屬於真核生物域中的變形蟲總群。其生命週期分為兩個主要階段:營養階段和繁殖階段。在營養階段,黏菌以原質團的形式存在,通常生長在陰暗潮濕的環境中,會通過吞噬有機物來獲取能量。而在繁殖階段,它們會移動到較為乾燥和明亮的地方,進行孢子的散播。有傳言指黏菌有出色的學習能力,甚至會自殺。專家解釋黏菌生死循環快速,所謂的自殺是自然地進入了繁殖階段。
飼養黏菌的原因
許多年輕人選擇養黏菌作為寵物,主要是因為它們能夠提供情感上的慰藉和減壓效果。內地年青人因工作壓力大而開始飼養黏菌,她認為這種生物不需要過多關注,適合忙碌的生活方式。
黏菌熱潮的興起
隨著社交媒體的普及,黏菌逐漸成為新一代寵物愛好者的焦點。最初購買者多為年輕人,但最近小學生也加入了這股潮流。這一現象引起了心理專家的關注,他們認為當代年輕人面臨著巨大的學習和就業壓力,因此轉向低成本、易於維護的寵物來尋求情感支持。
UTravel熱門旅遊話題
↓立即登記參加!賺取無上限現金賞💰↓
↓即睇最新行程懶人包、爆紅打卡點🔥、必吃美食😋等↓